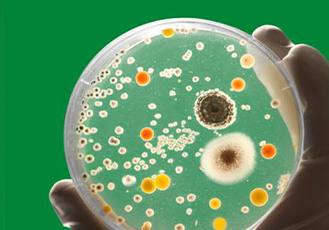

About Us
We are based in Amanzimtoti and offer a wide range of products and services such as high-quality detergents & personal hygiene products, cleaning service and food safety consultation. We pride ourselves on our excellent cleaning products, efficient services, competitive pricing and excellent overall customer services. We offer a whole spectrum of hygiene and cleaning solution for commercial and households.
We listen to our client’s needs and provide knowledgeable, experienced advise in offering successful solutions to solve their hygiene needs quickly and efficiently. The primary operations of the business were manufacturing and supply of cleaning and personal hygiene products, over the years, the business has expanded into detergent training, upholstery cleaning, as well food safety consultation where we assist food and packaging manufacturing companies to comply to Food Safety standard such as FSC22000 and HACCP, which is what the managing director of the company is qualified for.
To be considered the best service provider for detergents, personal care products, cleaning and food safety consultations. Striving to provide consistent quality products and services with a high level of professionalism, efficiency, reliability and affordability that exceed our customer expectations.
Through constant innovation,
we will always improve the quality of our products and services to make sure that we keep our
customers satisfied.
We also seek to improve the quality of life of our community members by giving them job opportunities.

CLEANFEST manufacture and supply quality house-holds detergents. Our products are well formulated
and balanced pH with high cleaning efficacy and high foam.
LEARN MORE

CLEANFEST has a compliment and experienced carpet and Upholstery cleaners. We use high quality industrial
grade machinery and laboratory tested detergents.
LEARN MORE
Assist food and packaging manufacturing companies to comply to Food Safety standard such as FSC22000 and HACCP
which is what the managing director of the company is qualified for.
LEARN MORE
Creating a happy environment through hygiene.